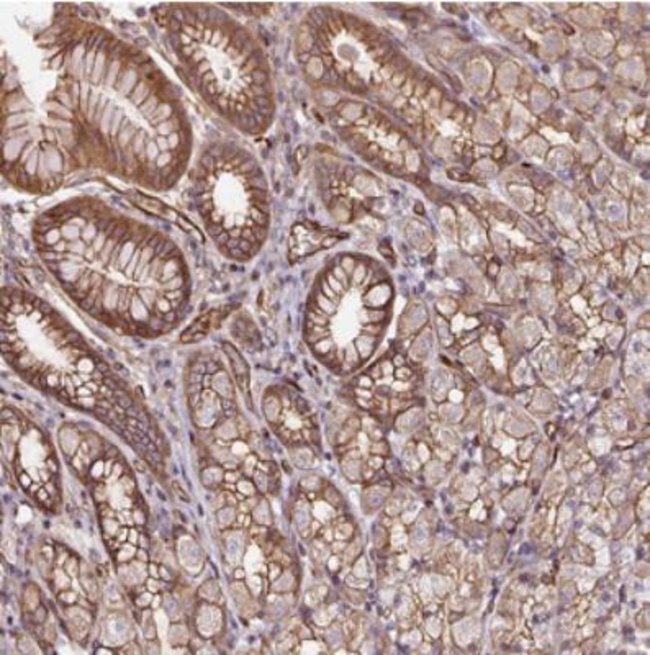

anti-B3GALT5, Polyclonal, Rabbit Polyclonal Antibody, Each
$ 847.13
|
Details
B3GALT5 Polyclonal specifically detects B3GALT5 in Human samples. It is validated for Immunohistochemistry, Immunohistochemistry-Paraffin.
Additional Information
SKU | 10337894 |
---|---|
UOM | Each |
UNSPSC | 12352203 |
Manufacturer Part Number | NBP230906 |